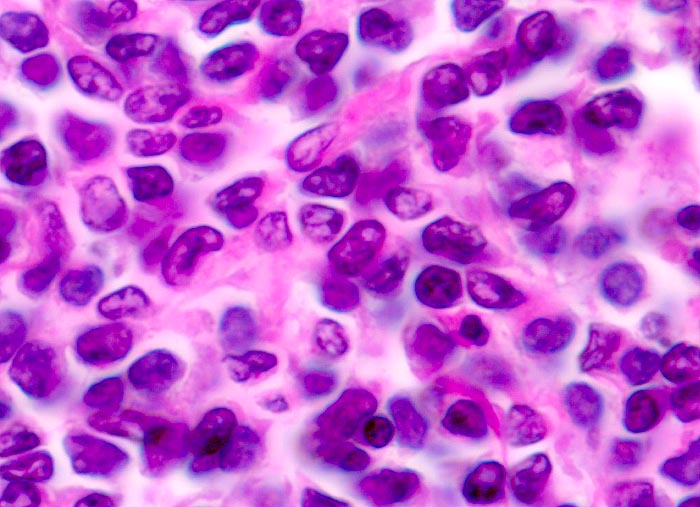

PathoPic – image database / PathoPic ID 3335 - extranodales Marginalzonenlymphom vom MALT-Typ
de
Diagnose
extranodales Marginalzonenlymphom vom MALT-Typ
Diagnose Gruppe
maligner Tumor
Topographie
Magen
Topographie Gruppe
Oesophagus, Magen
Beschreibung
Die neoplastischen Zellen zeigen eine monozytoide Differenzierung. Die Kerne sind länglich und teils gekerbt. Reichlich eosinophiles Zytoplasma.
Kommentar
Die Zellen des MALT Lymphoms können zentrozytoid, monozytoid, lymphozytoid oder plasmazellulär differenziert sein. Diese Vielgestalt der Morphologie kann die Differentialdiagnose mit anderen kleinzelligen B-Zell Lymphomen erschweren.
Bilder Typ
Histologie
Vergrösserung
630
Alter
78
Geschlecht
männlich
Datum
Ersteintrag: 12.11.2001